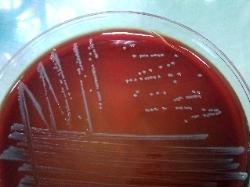

| Genus Providencia |
| Providencia stuartii cells; Gram staining. |
| Providencia stuartii colonies on Sheep Blood Agar |
Taxonomy
Morphology
Cultural characteristics
Biochemical characters
Ecology
Pathogenicity
References
Phylum Pseudomonadota (Proteobacteria), Class Gammaproteobacteria, Order Enterobacterales, Family Morganellaceae, Genus
Providencia, species:
- Providencia alcalifaciens Ewing 1962 - type species of the genus. Synonyms: Proteus inconstans (Ornstein 1920) Shaw and Clarke
1955, Eberthella alcalifaciens, de Salles Gomes 1944;
- Providencia burhodogranariea Juneja and Lazzaro 2009;
- Providencia heimbachae Müller et al. 1986;
- Providencia rettgeri Brenner et al. 1978, synonyms: Bacterium rettgeri Hadley 1918, Proteus rettgeri Rustigian & Stuart 1943;
- Providencia rustigianii Hickman-Brenner et al. 1983, synonym: Providencia friedericiana Müller 1983;
- Providencia sneebia Juneja and Lazzaro 2009;
- Providencia stuartii Ewing 1962, old synonm: Proteus stuartii Buttiaux et al. 1954;
- Providencia vermicola Somvanshi et al. 2006
Providencia, species:
- Providencia alcalifaciens Ewing 1962 - type species of the genus. Synonyms: Proteus inconstans (Ornstein 1920) Shaw and Clarke
1955, Eberthella alcalifaciens, de Salles Gomes 1944;
- Providencia burhodogranariea Juneja and Lazzaro 2009;
- Providencia heimbachae Müller et al. 1986;
- Providencia rettgeri Brenner et al. 1978, synonyms: Bacterium rettgeri Hadley 1918, Proteus rettgeri Rustigian & Stuart 1943;
- Providencia rustigianii Hickman-Brenner et al. 1983, synonym: Providencia friedericiana Müller 1983;
- Providencia sneebia Juneja and Lazzaro 2009;
- Providencia stuartii Ewing 1962, old synonm: Proteus stuartii Buttiaux et al. 1954;
- Providencia vermicola Somvanshi et al. 2006
Gram-negative rods, 0.6–0.8 x 1.5–2.5 μm. Motile.
Colonies are up to 4 mm in diameter,white, opaque, glossy and convex. After 24–48 h
of growth, colonies of P. burhodogranariea express a brown pigmentation in their
centres. P. vermicola produce a soluble brown pigment, colouring the medium
around the colonies. Facultatively anaerobic, optimum growth temperature 37 ºC.
Media: Nutrient agar, Luria-Bertani agar, Trypticase Soy Agar ± 5% sheep blood, BHI
agar.
of growth, colonies of P. burhodogranariea express a brown pigmentation in their
centres. P. vermicola produce a soluble brown pigment, colouring the medium
around the colonies. Facultatively anaerobic, optimum growth temperature 37 ºC.
Media: Nutrient agar, Luria-Bertani agar, Trypticase Soy Agar ± 5% sheep blood, BHI
agar.
Isolated from nature (water) and from clinical (urine, feces, blood, wounds & throat)
human & animal samples (mammals, birds, reptiles & insects).
P. burhodogranariea and P. sneebia were obtained from the haemolymph of
Drosophila melanogaster (fruit fly).
P. heimbachae has been isolated from penguin feces and an aborted bovine fetus.
P. vermicola has been isolated from the nematode Steinernema thermophilum.
human & animal samples (mammals, birds, reptiles & insects).
P. burhodogranariea and P. sneebia were obtained from the haemolymph of
Drosophila melanogaster (fruit fly).
P. heimbachae has been isolated from penguin feces and an aborted bovine fetus.
P. vermicola has been isolated from the nematode Steinernema thermophilum.
May cause diarrhea & nosocomial infections (urinary infections).
P. alcalifaciens, P. rettgeri, and P. stuartii can cause enteritis – “travelers' diarrhea”
(foodborne infections).
Reported case of P. rettgeri meningitis in crocodiles .
Providencia spp. are serologically related to Escherichia coli, Proteus, Morganella, Salmonella & Shigella species. The O-antigenic
specificity is defined by the structure of the O-antigen, a part of the lipopolysaccharide (LPS, endotoxin), one of the major components
of the outer membrane of Gram-negative bacteria. LPS is considered an important virulence factor.
P. alcalifaciens, P. rettgeri, and P. stuartii can cause enteritis – “travelers' diarrhea”
(foodborne infections).
Reported case of P. rettgeri meningitis in crocodiles .
Providencia spp. are serologically related to Escherichia coli, Proteus, Morganella, Salmonella & Shigella species. The O-antigenic
specificity is defined by the structure of the O-antigen, a part of the lipopolysaccharide (LPS, endotoxin), one of the major components
of the outer membrane of Gram-negative bacteria. LPS is considered an important virulence factor.
- J. G. Holt et al., 1994. Facultatively Anaerobic Gram-Negative Rods. Subgroup 1. Family Enterobacteriaceae. In: Begey’s Manual of
Determinative Bacteriology, 9th-edition, Williams & Wilkins, pp 175-189. - Ewing W.H.: The tribe Proteae: its nomenclature and taxonomy. International Bulletin of Bacteriological Nomenclature and
Taxonomy, 1962, 12, 93-102. - Muller H.E.: Providencia friedericiana, a new species isolated from penguins. Int. J. Syst. Bacteriol., 1983, 33, 709-715.
- Muller H.E., O’Hara C.M., Fanning G.R., Hickman-Brenner F.W., Swenson J.M. & Brenner D.J.: Providencia heimbachae, a new
species of Enterobacteriaceae isolated from animals. Int. J. Syst. Bacteriol., 1986, 36, 252-256. - Brenner D.J., Farmer III J.J., Fanning G.R., Steigerwalt A.G., Klykken P., Wathen H.G., Hickman F.W. & Ewing W.H.:
Deoxyribonucleic acid relatedness in species of Proteus and Providencia. International Journal of Systematic Bacteriology, 1978,
28, 269-282. - Hickman-Brenner F.W., Fanning G.R., Muller H.E. & Brenner D.J.: Priority of Providencia rustigianii Hickman-Brenner, Farmer,
Steigerwalt, and Brenner 1983 over Providencia friedericiana Müller 1983. Int. J. Syst. Bacteriol., 1986, 36, 565. - Ewing W.H.: The tribe Proteae: its nomenclature and taxonomy. International Bulletin of Bacteriological Nomenclature and
Taxonomy, 1962, 12, 93-102. - Somvanhi V.S. et al.: Providencia vermicola sp. nov., isolated from infective juveniles of the entomopathogenic nematode
Steinernema thermophilum. Int. J. Syst. Evol. Microbiol., 2006, 56, 629-633. - M. John Albert, A. S. G. Faruque, & D. Mahalanabis: Association of Providencia alcalifaciens with Diarrhea in Children, Journal of
Clinical Microbiology, May 1998, p. 1433-1435, Vol. 36, No. 5; - Punita Juneja and Brian P. Lazzaro: Providencia sneebia sp. nov. and Providencia burhodogranariea sp. nov., isolated from wild
Drosophila melanogaster. Int J Syst Evol Microbiol May 2009 59:1108-1111; - Don J. Brenner & J.J. Farmer III, 2004, Family I. Enterobacteriaceae, In: Bergey’s Manual of Systematic Bacteriology, Second
edition, Vol two, part B, George M. Garrity (Editor-in-Chief), pp. 740-744. - Adeolu M, Alnajar S, Naushad S, S Gupta R. Genome-based phylogeny and taxonomy of the 'Enterobacteriales': proposal for
Enterobacterales ord. nov. divided into the families Enterobacteriaceae, Erwiniaceae fam. nov., Pectobacteriaceae fam. nov.,
Yersiniaceae fam. nov., Hafniaceae fam. nov., Morganellaceae fam. nov., and Budviciaceae fam. nov. Int J Syst Evol Microbiol
2016; 66:5575-5599.
Closely related to Proteus spp.
Positive results for catalase, nitrates reduction, acid production from glucose and
D-mannose.
Negative results for beta-galactosidase, arginine dihydrolase, lysine decarboxylase,
ornithine decarboxylase, DN-ase, lipase, H2S production, oxidase, Voges-Proskauer
reaction, phenylalanine deaminase, gelatin hydrolysis, malonate utilization, acid
production from L-arabinose, cellobiose, dulcitol, lactose, melibiose, raffinose and
D-sorbitol.
Positive results for catalase, nitrates reduction, acid production from glucose and
D-mannose.
Negative results for beta-galactosidase, arginine dihydrolase, lysine decarboxylase,
ornithine decarboxylase, DN-ase, lipase, H2S production, oxidase, Voges-Proskauer
reaction, phenylalanine deaminase, gelatin hydrolysis, malonate utilization, acid
production from L-arabinose, cellobiose, dulcitol, lactose, melibiose, raffinose and
D-sorbitol.

(c) Costin Stoica

| Antibiogram |
| Encyclopedia |
| Culture media |
| Biochemical tests |
| Stainings |
| Images |
| Movies |
| Articles |
| Identification |
| Software |
| R E G N U M PROKARYOTAE |
|
Legend: + positive 90-100%, - negative 90-100%, [+] positive 75-89%, [-] negative 75-89%, d positive 25-74% of strains,
Differential characters of Providencia species:


| Back |